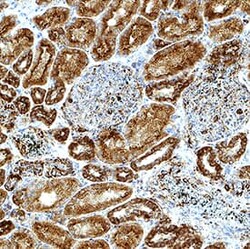
Human AMPK 1 Antibody, Novus Biologicals 25 &mu;g | Buy Online | R&D Systems | Fisher Scientific

Learn More
Human AMPKβ1 Antibody, Novus Biologicals™
Description
Specifications
Specifications
| Antigen | AMPK beta 1 |
| Applications | Western Blot, Immunohistochemistry, Simple Western |
| Classification | Monoclonal |
| Clone | 1092531 |
| Conjugate | Unconjugated |
| Dilution | Western Blot 1 μg/mL, Simple Western 10 μg/mL, Immunohistochemistry 0.5-25 μg/mL |
| Formulation | Lyophilized from a 0.2μm filtered solution in PBS with Trehalose. See Certificate of Analysis for details. *Small pack size (-SP) is supplied either lyophilized or as a 0.2μm filtered solution in PBS. |
| Gene Accession No. | Q9Y478 |
| Gene Alias | 5'-AMP-activated protein kinase beta-1 subunit, AMP-activated protein kinase beta subunit, AMPK, AMPK beta -1 chain, AMPK beta 1,5'-AMP-activated protein kinase subunit beta-1, AMPK subunit beta-1, AMPKb, HAMPKb, MGC17785, PRKAB1, protein kinase, AMP-activated, beta 1 non-catalytic subunit, protein kinase, AMP-activated, noncatalytic, beta-1 |
| Host Species | Mouse |
| Show More |
By clicking Submit, you acknowledge that you may be contacted by Fisher Scientific in regards to the feedback you have provided in this form. We will not share your information for any other purposes. All contact information provided shall also be maintained in accordance with our Privacy Policy.